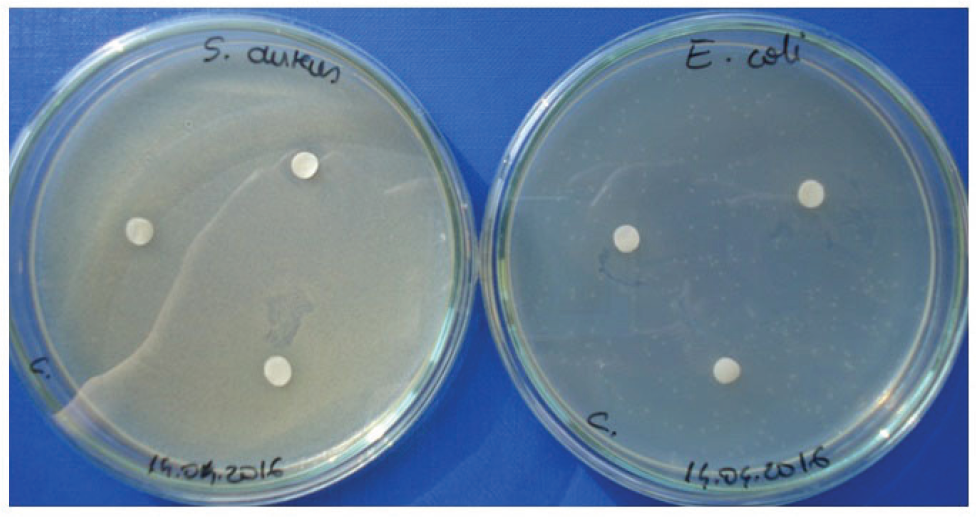
Figure 1 Determination of bacterial sensitivity (A - Staphylococcus aureus, B - Escherichia coli) in discs impregnated with A. cepa liquid extract, after 72 hours of incubation.
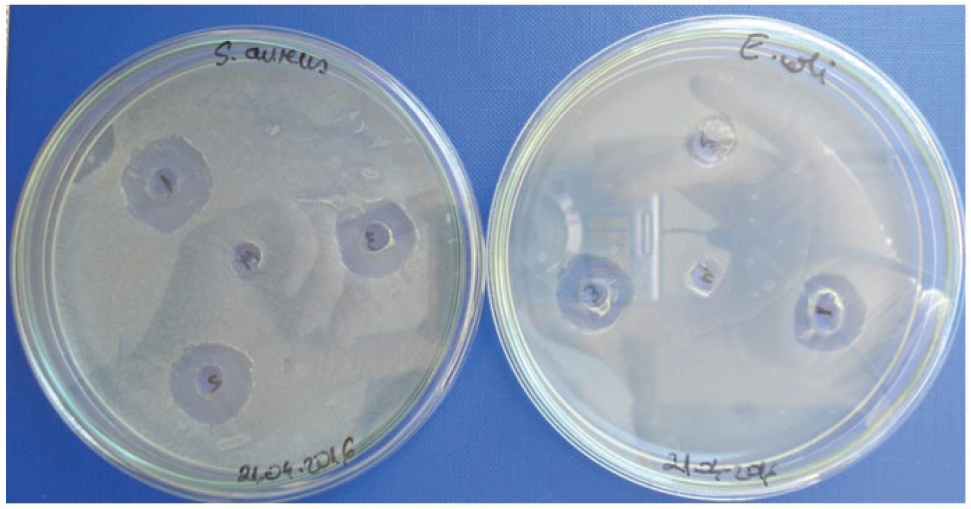
Figure 2 Determination of bacterial sensitivity (A - Staphylococcus aureus, B - Escherichia coli) in A. cepa liquid extract in wells, at 48 hours of incubation.
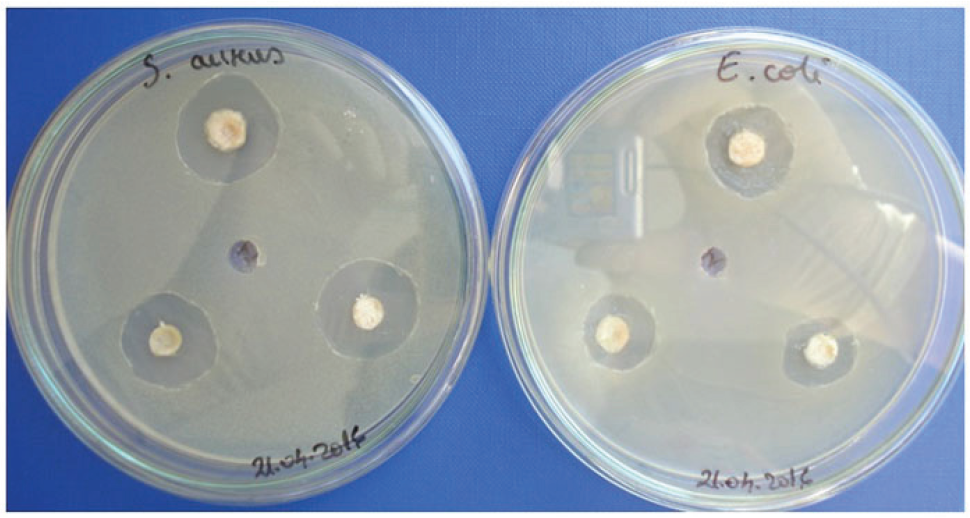
Figure 3 Determination of bacterial sensitivity (A - Staphylococcus aureus, B - Escherichia coli) in the lyophilized formulation based on onion extract transformed by incorporation of ultrapure water, at 48 hours of incubation.

Abstract
Background
Allium species extracts including Allium cepa L. contain sulfur compounds, known for their antiplatelet, antimicrobial, antineoplasic activities.
Methodology
Antibacterial activity of a formulation based on A. cepa extracts-liquid and lyophilized samples, has been demonstrated using two classes of bacteria: Gram-positive (Staphylococcus aureus) and Gram-negative (Escherichia coli) and three methods: discs soaked with liquid extract, the wells method in the culture medium, filled with the liquid extract and lyophilized formulation extracts transformed by the incorporation of ultrapure water. The second part of this study includes identification of thiosulfinates compounds from the studied samples by high performance liquid chromatography - mass spectrometry (HPLC-MS).
Results
The most important inhibition and the highest antibacterial effficiency were observed against Gram-positive bacteria, such as Staphylococcus aureus. The HPLC-MS thiosulfinates profile of the tested formulation extracts shows the presence of seven thiosulfinate compounds, MeS(O)S 1-propenyl (E,Z); n-PrS(O)S 1-propenyl-(E); n-PrS(O)S 1-propenyl-(Z); trans-zwiebelane; n-PrS(O)CHEtSS-1propenyl; 1-propenylS(O)CHEtSS1-propenyl, which may be responsible for antibacterial activity.
Conclusion
Testing antimicrobial effects using the three mentioned methods confirmed the antimicrobial activity of the tested samples based on A. cepa extracts, with a demonstrated content of seven thiosulfinate compounds.
Introduction
Allium cepa L. varieties and other Allium species contain sulfur compounds that give them their flavor and aroma. They are obtained by disruption of the cell structure of a precursor compound - S-alkenyl cysteine sulfoxide, which reacts with she enzyme alliinase. This enzyme cleaves the precursor, forming sulfenic alkyl acids. These intermediate alkyl sulfenic acids are rapidly converted into thiosulfinate compounds. In onions, the predominant compound 1-propenyl-sulfenic acid turns especially into (Z, E) thiopropanal-S-oxide, zwiebelanes and tear factor, isomers of di(1-propenyl) thiosulfinate [1]. Other sulfenic acids condense into thiosulfinates that appear to be responsible for the smell of freshly cut onions. Thiosulfinates are relatively unstable and they rearrange into polysulfides, thiosulfonates and other compounds [1-3]. Qualitative and quantitative analysis of Allium organosulfur compounds depends on isolation and the analytical methods involved - gas chromatography-mass spectrometry (GC-MS), high performance liquid chromatography with diode array detection (HPLC-DAD), nuclear magnetic resonance (NMR), high performance liquid chromatography-mass spectrometry (HPLC-MS), liquid chromatography-atmospheric pressure chemical ionization-mass spectrometry (LC-APCI-MS) [1-8]. Thiopropanal-S-oxide, a compound responsible for tears, was analyzed directly from the juice of fresh onions (A. cepa) by solid phase microextraction and by GC-MS. Identification and quantification of thiosulfinates and zwiebelanes obtained in the same juice extracted with diethyl ether were performed using GC-MS [3]. In the literature, numerous similar studies are reported: identification of thiosulfinates in A. cepa samples using HPLC-DAD-tandem mass spectrometry [4]; quantification and identification of the most abundant species of metabolites in edible onions by NMR and HPLC-MS [5]; determination of volatile compounds in onion samples processed with gas chromatography-mass spectrometry (HSGC-MS) [6]. Supercritical fluid extracts of homogenized Allium species, garlic, ramp, and onion, were characterized with liquid chromatography (LC) and atmospheric pressure chemical ionization mass spectrometric identification [8].
Recent research has demonstrated that onions possess several biological properties, such as antibacterial [9], antimutagenic [10], antifungal [11], antimicrobial [12], antiplatelet [14] and antioxidant activities [10,12-14]. A. cepa essential oil shows a moderate antimicrobial activity against reference strains and also possesses an interesting antioxidant activity [12].
Antimicrobial Allium compounds differ depending on processing. When they are freshly crushed, various thiosulfinates are present; when crushed and stored, various dialk(en)yl sulfides are revealed. Allium extracts, which are expected to contain primarily thiosulfinates formed from sulfoxides, inhibit the growth of Gram-positive, Gram-negative, and acid-fast bacteria [15].
Antimicrobial activity against Staphylococcus aureus from methanolic and aqueous extracts of dried A. cepa (Liliaceae) bulbs was studied using the agar well diffusion method. Essential oil extracts of onion and garlic can be used as natural antimicrobial additives incorporated in various food products [16-17]. Given what was presented above, it is very important to study the antimicrobial activity of A. cepa formulations based on A. cepa extracts.
The aim of this paper was to study the antimicrobial activity and the HPLC-MS thiosulfinates profile of the A. cepa extract formulation using both the liquid and lyophilized extract of A. cepa, the white variety.
Experimental procedure
The studied samples used are extracts from white variety of A. cepa L., cultivated on soil from Maramureş region, Romania. The liquid sample was obtained according to the data mentioned in our previous studies [14]. The solid formulation tested was obtained from the liquid extract of A. cepa stabilized with excipients: silicon dioxide, zinc stearate and gelatine, at appropriate concentrations, as approved by the Food and Drug Administration (FDA) (liquid extract - 87.11%, SiO2 - 5.19%, Zn stearate - 1.51%, gelatine - 6.19%). The liquid extract with excipients was frozen and subsequently lyophilized using Lyophilizer - Model Alpha 1-4LDPLUS. The material tested further was the liquid extract and the lyophilized formulation - powder.
Antimicrobial assay
The disc diffusion method is based on the property of various test substances to diffuse into the solid culture medium. Discs are pieces of filter paper soaked with antibiotics. Placed on a solid culture medium, in which a bacterial culture has been inoculated, the substance diffuses into the environment around the disc. If the studied species is sensitive to the antibiotic or the antimicrobial substance, it will not develop around the disc, and the medium remains clear; the bacterial culture concerned will develop in the rest of the medium in the Petri dish.
Work technique
A bacterial culture in nutrient broth culture medium was obtained [18]. The dilution of the culture medium was 1%: 0.1 ml culture + 9.9 ml sterile medium. Each Petri dish was inoculated with 1 ml of the mentioned dilution. After coating the surface, the excess liquid was removed, by tilting, from the solid surface of the culture medium (Nutrient Agar). The dishes were dried at 37°C, for 1 hour. Sterile paper discs 6 mm in diameter were placed on the solid surface of the culture medium. Then, the discs were impregnated with 20 μl antimicrobial solution. They were incubated for 18-24 hours, at 37°C. Reading was done by measuring the diameter of the inhibition zone: if the diameter of the inhibition zone was larger, bacterial susceptibility to the tested antimicrobial substance was greater [19].
Three types of experiments were performed to test the antimicrobial activity of the onion extracts. Each test method used was performed in triplicate.
Method of discs soaked with A. cepa liquid extract
In the dishes with Nutrient Agar culture medium [18], the test strains (Staphylococcus aureus ATCC 25923 for Gram-positive bacteria and Escherichia coli ATCC 25922 for Gram-negative bacteria) were inoculated in aseptic conditions. For the inoculation of the test microorganisms, 1 ml bacterial suspension was used, which was applied on the entire surface of the medium. After drying of the inoculated medium, the paper discs were introduced. These discs were treated with 20 μl A. cepa extract two times. Then, the dishes were incubated at 37°C. After the incubation period, the results were evaluated by measuring the inhibition zone (mm) around the disc. Since no inhibition was observed at 24 or 48 hours, incubation was prolonged to 72 hours. After these 72 hours, the inhibition zones were determined for the tested strains.
Method of wells in the culture medium, filled with A. cepa liquid extract
In the Nutrient Agar [18] culture medium, 6 mm wells were made under aseptic conditions. Then, the test strains were inoculated (Staphylococcus aureus ATCC 25923 for Gram-positive bacteria and Escherichia coli ATCC 25922 for Gram-negative bacteria). For the inoculation of the test microorganisms, 1 ml bacterial suspension was used, which was applied on the entire surface of the medium. After drying of the inoculated medium, 15 μl liquid extract of A. cepa were introduced into each of three wells, and the well in the middle of the Petri dish was left empty, serving as a control. The dishes were then incubated at 37°C. At 48 hours of incubation, the inhibition zones were read.
Method of wells in the culture medium, filled with a lyophilized formulation based on onion extract transformed by incorporation of ultrapure water.
In the Nutrient Agar [18] culture medium, 6 mm wells were made under aseptic conditions. Then, the test strains were inoculated (Staphylococcus aureus ATCC 25923 for Gram-positive bacteria and Escherichia coli ATCC 25922 for Gram-negative bacteria).
For the inoculation of the test microorganisms, 1 ml bacterial suspension was used, which was applied on the entire surface of the medium. After drying of the inoculated medium, A. cepa extract obtained from onion extract-based formulations with ultrapure water was introduced into three wells. The well in the middle of the Petri dish was left empty and served as a control. The boxes were then incubated at 37°C. At 48 hours of incubation, the inhibition zones were read.
HPLC-MS equipment and method
For HPLC-MS analyses, an Agilent high performance liquid chromatograph 1200/2008 with detectors was used: VWD-G1314B and MS. For HPLC separation, a Zorbax Eclipse XDB-C18 column (4.6 x 150 mm, 5 µm) at 25°C was used. Methanol was purchased from Merck (Darmstadt, Germany). The water used for preparing the standard solution was Millipore water (18.2 MΩ cm-1). The gas was high purity He carrier gas. HPLC sample preparation: 1 gram of A. cepa formulation was dissolved in water (in a 10 ml flask), the solution was ultrasonicated for 15 minutes, then vacuum filtered with a filter of 0.45 µm, and injected into the HPLC.
The mobile phase was a mixture of water (A, ultrapure Millipore water) and methanol (B, HPLC grade), and a gradient was applied according to the following method: 0-2 min, isocratic 99% A, 2-6 min, linear gradient 99–94% A; 16–9 min, linear gradient 96–99% A; 9–15 min, isocratic 99% A. The flow rate was 0.5 ml min-1 and the injector volume was 20 ml. An MS detector of chemical ionization at atmospheric pressure (APCI) was used in positive mode of ionization [M-H]+. Nebulization was carried out at 300°C and 50 psi, under a nitrogen stream of 12L N2/min. Capillary voltage was set at 3000V. Thiosulfinates were qualitatively determined by recording the abundance of fragments m/z, 111 [MeS(O)SMe], 137 [MeS(O)S1-propenyl (E,Z), MeSS(O)1-propenyl-(E)], 163 [AllS(O)S1propenyl-(E,Z); cis, trans-zwiebelane], 165 [n-PrS(O)S1-propenyl-(E)], 211 [1-propenyS(O)CHEtSSMe], 237 [1-propenylS(O)CHEtSS1-propenyl], 239 [1-propenylS(O)CHEtSSPr-n]. Compounds were identified according to the reference [8].
Results and discussion
For a detailed description of the properties of the studied natural formulation, testing and quantifying of the antimicrobial effect is an important step, especially in the context of literature studies replete with information in this regard [11,12,15-17].
Antimicrobial activity
This study used qualitative disc diffusion methods. These methods are simple, quick and easy to perform, allowing sufficient guidance for practical and clinical needs. They have the advantage that they can be used for almost all antimicrobials. This method relies on the property of antibiotics or antimicrobials to disseminate in the culture medium (Nutrient Agar), creating a circular area where antibiotic concentrations decrease from the center to the periphery. When working with decreasing concentrations of antibiotics, the sensitivity of the studied germ can be appreciated by comparison with a standard strain, total or only partial inhibition being obtained.
Method of discs soaked with A. cepa liquid extract
It was noted that both the Gram-positive strain (Staphylococcus aureus ATCC 25923) and the Gram-negative strain (Escherichia coli ATCC 25922) had no zones of inhibition around the disc. However, Staphylococcus aureus showed a weak (7 mm), not very well defined inhibition.
Method of wells in the culture medium, filled with A. cepa liquid extract
Bacterial growth inhibition zones can be observed in all three wells for both Gram-positive and Gram-negative bacteria. However, there are some differences between the tested bacterial strains. The average of the triplicate assessments shows that the sensitivity of Gram-positive bacteria (Staphylococcus aureus) is much higher (18 mm) compared to that of Gram-negative bacteria (Escherichia coli), whose average value reaches 14.3 mm.
Method of wells in the culture medium, filled with a lyophilized formulation based on onion extract transformed by incorporation of ultrapure water.
Bacterial growth inhibition zones can be seen in all three wells for both the Gram-positive and Gram-negative bacteria. This antimicrobial test method also evidences a difference between the tested strains. The average of the triplicate assessments shows that this time the sensitivity of Gram-positive bacteria (Staphylococcus aureus) is higher (20.66 mm) compared to that of Gram-negative bacteria (Escherichia coli) (16 mm).
Regarding the antibacterial effect of A. cepa extracts, many authors have demonstrated both an individual antimicrobial and antifungal effect, and a synergistic effect with other antibiotics or antifungals [11]. The higher antimicrobial effects demonstrated in the case of the lyophilized extract of A. cepa, stabilized with the excipients mentioned in the previous study, could be explained by the greater amount of extract in the case of the lyophilized sample compared to the liquid sample, and by the use of zinc stearate, known for its antibacterial properties, as an excipient [20].
This study, through the promising antimicrobial effects of the Allium extract, supports and strengthens the results of other studies that have shown an intense antibacterial effect on various microorganisms tested, with significant minimum inhibitory concentration values (MIC) [12]. It has been suggested that essential oils of A. cepa can be a potential source of natural antimicrobial agents.
The tested antimicrobial effects of the studied samples (liquid extract compared to the lyophilized and stabilized formulation) and the inhibition zone diameter in these experiments are shown in Table 1.
Inhibition zone diameter (mm) of A. cepa extracts for the tested bacteria.
| Method used | Sample | Inhibition zone diameter (mm) Staphylococcus aureus ATCC 25923 | Escherichia coli ATCC 25922 |
|---|---|---|---|
| Method of discs soaked with liquid extract of | 1 | 7 | 0 |
| Allium cepa L | 2 | 7 | 0 |
| 3 | 7 | 0 | |
| Method of wells in the culture medium filled with | 1 | 20 | 16 |
| liquid extract of Allium cepa L. | 2 | 18 | 11 |
| 3 | 16 | 16 | |
| Method of wells in the culture medium filled with | 1 | 20 | 16 |
| lyophilized formulation based on onion extract | 2 | 21 | 15 |
| transformed by the incorporation of ultrapure | |||
| water | 3 | 21 | 17 |
HPLC-MS thiosulfinates profile study
Under APCI of MS detector with methanol / water mobile phase, the mass spectra of the thiosulfinates have a base peak coresponding to the protonated molecule [M-H]+. The Table 2 shows the HPLC-MS data of thiosulfinates found in formulations based on A. cepa extract.
Determination of bacterial sensitivity (A - Staphylococcus aureus, B - Escherichia coli) in discs impregnated with A. cepa liquid extract, after 72 hours of incubation.
Determination of bacterial sensitivity (A - Staphylococcus aureus, B - Escherichia coli) in A. cepa liquid extract in wells, at 48 hours of incubation.
Determination of bacterial sensitivity (A - Staphylococcus aureus, B - Escherichia coli) in the lyophilized formulation based on onion extract transformed by incorporation of ultrapure water, at 48 hours of incubation.
Thiosulfinate compounds identified in the formulation based on A. cepa lyophilized extract.
| RT [min] | Area % | Thiosulfinate compounds[a] | No. compound [8] / Molecular structure | m/z of [M-H]+ ions (relative abundance) |
| 2.161 | 69.527 | MeS(O)S 1-propenyl (E,Z) | 4;5![]() | 73 (25); 137.1 (100) |
| 2.996 | 16.883 | |||
| 3.431 | 5.089 | n-PrS(O)S 1-propenyl-(E) | 15![]() | 73 (25); 165 (100) |
| 3.651 | 4.077 | n-PrS(O)S 1-propenyl-(Z) | 16![]() | 73 (25); 165 (100) |
| 5.542 | 2.348 | trans-zwiebelane | 21![]() | 113 (81); 163 (100) |
| 7.125 | 1.362 | n-PrS(O)CHEtSS-1propenyl | 27![]() | 105 (100); 239 (39) |
| 8.041 | 0.713 | 1-propenylS(O)CHEtSS1-propenyl | 25![]() | 105.2 (100); 237 (32) |
The HPLC-MS study of the thiosulfinates profile of the A. cepa extract formulation shows the presence of seven thiosulfinates, mentioned in Fig. 4 and Table 2.

HPLC-MS thiosulfinates profile of the A. cepa extract - lyophilized formulations; 4;5, MeS(O)S 1-propenyl (E,Z); 15, n-PrS(O)S 1-propenyl-(E); 16, n-PrS(O)S 1-propenyl-(Z); 21, trans-zwiebelane; 27, n-PrS(O)CHEtSS-1propenyl; 25, propenylS(O)CHEtSS1-propenyl
Thiosulfinate compounds were identified according to the reference [8]. Seven thiosulfinates were found in the A. cepa extract: MeS(O)S 1-propenyl (E,Z), n-PrS(O)S 1-propenyl-(E), n-PrS(O)S 1-propenyl-(Z), trans-zwiebelane, n-PrS(O)CHEtSS 1-propenyl, 1-propenylS(O)CHEtSS1-propenyl, which can be responsible for antimicrobial activity in the studied samples. The chromatogram in Fig. 4 shows that MeS(O)S 1-propenyl (E,Z) compounds are the majority (peak area 84.41%).
Conclusions
Testing of the antimicrobial effects of A. cepa extracts using the three mentioned methods confirmed their antimicrobial activity. A minor antimicrobial effect of the A. cepa liquid extract was observed by using the method of discs soaked with onion extract, with a minimum inhibition for Staphylococcus aureus.
A significant antibacterial efficiency was demonstrated for both the liquid and lyophilized formulation extracts using the method of wells in the culture medium, filled with the liquid extract and with the lyophilized formulation based on onion extract transformed by incorporation of ultrapure water, respectively. The most important inhibition and the highest antimicrobial efficiency were observed against Gram-positive bacteria, such as Staphylococcus aureus.
The thiosulfinates profile of the lyophilized formulation, using the HPLC-MS method, shows the presence of seven thiosulfinate compounds: MeS(O)S1-propenyl (E,Z); n-PrS(O)S1-propenyl-(E); n-PrS(O)S1-propenyl-(Z); trans-zwiebelane; n-PrS(O)CHEtSS-1propenyl; 1-propenylS(O)CHEtSS1-propenyl, with MeS(O)S1-propenyl (E,Z) being the dominant compound. These compounds appear to be responsible for antimicrobial activity.
Acknowledgments
This work was supported by the Programme of Research, Development and Innovation PNCDI II, Grant number PN-II-PT-PCCA-2013-4-1198, and a PhD scholarship.
References
[1] Block E., Putman D., Zhao S.H., Allium chemistry: GC-MS analysis of thiosulfinates and related compounds from onion, leek, scallion, shallot, chive, and Chinese chive, J. Agric. Food Chem., 1992, 40, 2431.10.1021/jf00024a018Search in Google Scholar
[2] Arnault I., Mondy N., Cadoux F., Auger J., Possible interest of various sample transfer techniques for fast gas chromatography-mass spectrometric analysis of true onion volatiles, J. Chromatogr. A, 2000, 896, 117–124.10.1016/S0021-9673(00)00365-4Search in Google Scholar
[3] Mondy N., Duplat D., Christides J.P., Arnault I., Auger J., Aroma analysis of fresh and preserved onions and leek by dual solid-phase microextraction-liquid extraction and gas chromatography-mass spectrometry. J. Chromatogr. A, 2002, 963, 89–93.10.1016/S0021-9673(02)00221-2Search in Google Scholar
[4] Lee E.J., Rezenom Y.H., Russell D.H., Patil B.S., Yoo K.S., Elucidation of chemical structures of pink-red pigments responsible for ‘pinking’ in macerated onion (Allium cepa L.) using HPLC–DAD and tandem mass spectrometry, Food Chem., 2012, 131, 852–861.10.1016/j.foodchem.2011.09.059Search in Google Scholar
[5] Soininen T.H., Jukarainen N., Auriola S.O.K., Julkunen-Tiitto R., Karjalainen R., Vepsäläinen J.J., Quantitative metabolite profiling of edible onion species by NMR and HPLC-MS, Food Chem., 2014, 165, 499-505.10.1016/j.foodchem.2014.05.132Search in Google Scholar
[6] Colina-Coca C, Gonzalez-Pena D., Vega E., De Ancos B., Sanchez-Moreno C., Novel approach for the determination of volatile compounds in processed onion by head space gas chromatography-mass spectrometry (HSGC-MS), Talanta, 2013, 103, 137-144.10.1016/j.talanta.2012.10.022Search in Google Scholar
[7] Mandon N., Brohard-Bohn B., Pain S., Jaillais B., Rendu F., Auger J., Fast narrow-bore HPLC analysis of thiosulfinates in onions and hybrids. Relationships with the platelet anti-aggregant activity, Biochem. Chromatogr., 2000, 14, 53-55.10.1002/(SICI)1099-0801(200002)14:1<53::AID-BMC968>3.0.CO;2-RSearch in Google Scholar
[8] Calvey E.M., Matusik J.E., White K.D., DeOrazio R., Sha D., Block E., Allium chemistry: Supercritical Fluid Extraction LC-APCI-MS of Thiosulfinates and Related Compounds from Homogenates of Garlic, Onion, and Ramp. Identification in Garlic and Ramp and Synthesis of 1-Propanesulfinothioic Acid S-Allyl Ester, J. Agric. Food Chem., 1997, 45, 4406-4413.10.1021/jf970314eSearch in Google Scholar
[9] Griffiths G., Trueman L, Crowther T., Thomas B., Smith, B. Onions - a global benefit to health, Phytother. Res., 2002, 16(7), 603-615.10.1002/ptr.1222Search in Google Scholar
[10] Singh B.N., Singh B.R., Singh L, Prakash D., Singh D.P., Sarma B.K., et al., Polyphenolics from various extracts/fractions of red onion (Allium cepa) peel with potent antioxidant and antimutagenic activities, Food & Chem. Toxicol., 2009, 47, 1161-1167.10.1016/j.fct.2009.02.004Search in Google Scholar
[11] Pyun M.S., Shin S., Antifungal effects of the volatile oils from Allium plants against Trichophyton species and synergism of the oils with ketoconazole, Phytomedicine, 2006, 13(6), 394-400.10.1016/j.phymed.2005.03.011Search in Google Scholar PubMed
[12] Chun-Lin Y., De-Hui D., Wei-Lian H., Antimicrobial and antioxidant activities of the essential oil from onion (Allium cepa L.), Food Control, 2013, 30(1), 48–53.10.1016/j.foodcont.2012.07.033Search in Google Scholar
[13] Dini I., Tenore G.C., Dini A., S-alkenyl cysteine sulfoxide and its antioxidant properties from Allium cepa var. tropeana (red onion) seeds, J. Nat. Prod., 2008, 71(12), 2036-2037.10.1021/np800237wSearch in Google Scholar PubMed
[14] Saplonţai-Pop A., Moţ A., Moldovan M., Oprean R., Silaghi-Dumitrescu R., Orǎşan O., et al., Testing antiplatelet and antioxidant activity of the extract of seven varieties of Allium cepa L., Open Life Sciences, 2015, 10, 89–98.10.1515/biol-2015-0011Search in Google Scholar
[15] Kyung K.H., Antimicrobial properties of Allium species, Current Opinion in Biotechnology, 2012, 23, 142-147.10.1016/j.copbio.2011.08.004Search in Google Scholar PubMed
[16] Eltaweel M., Assessment of Antimicrobial Activity of Onion Extract (Allium cepa) on Staphylococcus aureus; in vitro study, International Conference on Chemical, Agricultural and Medical Sciences (CAMS-2013) 29-30 Dec 2013, Kuala, Lumpur (Malaysia), 2013, 1-3.Search in Google Scholar
[17] Benkeblia N., Antimicrobial activity of essential oil extracts of various onions (Allium cepa) and garlic (Allium sativum), LWT -Food Science and Technology, 2004, 37(2), 263–268.10.1016/j.lwt.2003.09.001Search in Google Scholar
[18] Atlas R.M. ”Handbook of Microbiological Media”, 4th Edition, CRC Press, New York, 2010.10.1201/EBK1439804063Search in Google Scholar
[19] Carpa R., Drǎgan-Bularda M., Muntean V., „Microbiologie Generalǎ - Lucrǎri Practice”, Ed. Presa Univ. Clujeanǎ, 2014.Search in Google Scholar
[20] Niazi S.K. “Handbook of Pharmaceutical Manufacturing Formulations: Over-the-Counter Products”, vol5, 2nd edition, Ed. Informa Healthcare, New York, 2009.Search in Google Scholar
© 2017 O. Orăşan et al.
This work is licensed under the Creative Commons Attribution-NonCommercial-NoDerivatives 3.0 License.
Articles in the same Issue
- Regular Articles
- Rare Coumarins Induce Apoptosis, G1 Cell Block and Reduce RNA Content in HL60 Cells
- Regular Articles
- Evaluation of the photocatalytic ability of a sol-gel-derived MgO-ZrO2 oxide material
- Regular Articles
- Extraction Methods for the Isolation of Isoflavonoids from Plant Material
- Regular Articles
- Micro and nanocomposites of polybutadienebased polyurethane liners with mineral fillers and nanoclay: thermal and mechanical properties
- Regular Articles
- Effect of pH on Structural, Magnetic and FMR Properties of Hydrothermally Prepared Nano Ni Ferrite
- Regular Articles
- Statistical approach to study of lithium magnesium metaborate glasses
- Regular Articles
- The effectiveness of biodrying waste treatment in full scale reactor
- Regular Articles
- Chemical comparison of the underground parts of Valeriana officinalis and Valeriana turkestanica from Poland and Kazakhstan
- Regular Articles
- Phytochemical Characterization and Biological Evaluation of the Aqueous and Supercritical Fluid Extracts from Salvia sclareoides Brot
- Regular Articles
- Recent Microextraction Techniques for Determination and Chemical Speciation of Selenium
- Regular Articles
- Compost leachate treatment using polyaluminium chloride and nanofiltration
- Regular Articles
- Facile and Effective Synthesis of Praseodymium Tungstate Nanoparticles through an Optimized Procedure and Investigation of Photocatalytic Activity
- Regular Articles
- Computational Study on Non-linear Optical and Absorption Properties of Benzothiazole based Dyes: Tunable Electron-Withdrawing Strength and Reverse Polarity
- Regular Articles
- Comparative sorption studies of chromate by nano-and-micro sized Fe2O3 particles
- Regular Articles
- Recycling Monoethylene Glycol (MEG) from the Recirculating Waste of an Ethylene Oxide Unit
- Regular Articles
- Antimicrobial activity and thiosulfinates profile of a formulation based on Allium cepa L. extract
- Regular Articles
- The effect of catalyst precursors and conditions of preparing Pt and Pd-Pt catalysts on their activity in the oxidation of hexane
- Regular Articles
- Platinum and vanadate Bioactive Complexes of Glycoside Naringin and Phenolates
- Regular Articles
- Antimicrobial sesquiterpenoids from Laurencia obtusa Lamouroux
- Regular Articles
- Comprehensive spectroscopic (FT-IR, FT-Raman, 1H and 13C NMR) identification and computational studies on 1-acetyl-1H-indole-2,3-dione
- Regular Articles
- A combined experimental and theoretical study on vibrational and electronic properties of (5-methoxy-1H-indol-1-yl)(5-methoxy-1H-indol-2-yl)methanone
- Regular Articles
- Erratum to: Analysis of oligonucleotides by liquid chromatography with alkylamide stationary phase
- Regular Articles
- Non-isothermal Crystallization, Thermal Stability, and Mechanical Performance of Poly(L-lactic acid)/Barium Phenylphosphonate Systems
- Regular Articles
- Vortex assisted-supramolecular solvent based microextraction coupled with spectrophotometric determination of triclosan in environmental water samples
- Regular Articles
- Investigation on Two Compounds of O,O’-dithiophosphate Derivatives as Corrosion Inhibitors for Q235 Steel in Hydrochloric Acid Solution
- Regular Articles
- Evaluation of temporary seasonal variation of heavy metals and their potential ecological risk in Nzhelele River, South Africa
- Regular Articles
- Synthesis, characterization, second and third order non-linear optical properties and luminescence properties of 1,10-phenanthroline-2,9-di(carboxaldehyde phenylhydrazone) and its transition metal complexes
- Regular Articles
- Spectrodensitometric simultaneous determination of esomeprazole and domperidone in human plasma
- Regular Articles
- Computer-aided drug design of capuramycin analogues as anti-tuberculosis antibiotics by 3D-QSAR and molecular docking
- Regular Articles
- Synthesis, characterization, thermal degradation and urease inhibitory studies of the new hydrazide based Schiff base ligand 2-(2-hydroxyphenyl)-3-{[(E)-(2-hydroxyphenyl)methylidene]amino}-2,3-dihydroquinazolin-4(1H)-one
- Regular Articles
- Quaternary salts derived from 3-substituted quinuclidine as potential antioxidative and antimicrobial agents
- Regular Articles
- Bio-concentration of Polycyclic Aromatic Hydrocarbons in the grey Mangrove (Avicennia marina) along eastern coast of the Red Sea
- Regular Articles
- Quantitative Investigation of Roasting-magnetic Separation for Hematite Oolitic-ores: Mechanisms and Industrial Application
- Regular Articles
- Photobleaching characteristics of α-(8-quinolinoxy) zinc phthalocyanine, a new type of amphipathic complex
- Regular Articles
- Methane dry reforming over Ni catalysts supported on Ce–Zr oxides prepared by a route involving supercritical fluids
- Regular Articles
- Thermodynamic Compatibility, Crystallizability, Thermal, Mechanical Properties and Oil Resistance Characteristics of Nanostructure Poly (ethylene-co-methyl acrylate)/Poly(acrylonitrile-co-butadiene) Blends
- Regular Articles
- The crystal structure of compositionally homogeneous mixed ceria-zirconia oxides by high resolution X-ray and neutron diffraction methods
- Topical Issue on Agriculture
- Properties of the filtrate from treatment of pig manure by filtration method
- Topical Issue on Agriculture
- Monitoring content of cadmium, calcium, copper, iron, lead, magnesium and manganese in tea leaves by electrothermal and flame atomizer atomic absorption spectrometry
- Topical Issue on Catalysis
- Application of screen-printed carbon electrode modified with lead in stripping analysis of Cd(II)
- Topical Issue on Research for Natural Bioactive Products
- Burdock (Arctium lappa) Leaf Extracts Increase the In Vitro Antimicrobial Efficacy of Common Antibiotics on Gram-positive and Gram-negative Bacteria
- Topical Issue on Research for Natural Bioactive Products
- A survey of bacterial, fungal and plant metabolites against Aedes aegypti (Diptera: Culicidae), the vector of yellow and dengue fevers and Zika virus
- Topical Issue on Research for Natural Bioactive Products
- ‘Capiture’ plants with interesting biological activities: a case to go
- Topical Issue on Research for Natural Bioactive Products
- Volatile terpenoids as potential drug leads in Alzheimer’s disease
- Topical Issue on Research for Natural Bioactive Products
- Essential Oils as Immunomodulators: Some Examples
- Topical Issue on Research for Natural Bioactive Products
- Phenolic profiling and therapeutic potential of local flora of Azad Kashmir; In vitro enzyme inhibition and antioxidant
- Topical Issue on Research for Natural Bioactive Products
- Chemical profile, antioxidant activity and cytotoxic effect of extract from leaves of Erythrochiton brasiliensis Nees & Mart. from different regions of Europe
Articles in the same Issue
- Regular Articles
- Rare Coumarins Induce Apoptosis, G1 Cell Block and Reduce RNA Content in HL60 Cells
- Regular Articles
- Evaluation of the photocatalytic ability of a sol-gel-derived MgO-ZrO2 oxide material
- Regular Articles
- Extraction Methods for the Isolation of Isoflavonoids from Plant Material
- Regular Articles
- Micro and nanocomposites of polybutadienebased polyurethane liners with mineral fillers and nanoclay: thermal and mechanical properties
- Regular Articles
- Effect of pH on Structural, Magnetic and FMR Properties of Hydrothermally Prepared Nano Ni Ferrite
- Regular Articles
- Statistical approach to study of lithium magnesium metaborate glasses
- Regular Articles
- The effectiveness of biodrying waste treatment in full scale reactor
- Regular Articles
- Chemical comparison of the underground parts of Valeriana officinalis and Valeriana turkestanica from Poland and Kazakhstan
- Regular Articles
- Phytochemical Characterization and Biological Evaluation of the Aqueous and Supercritical Fluid Extracts from Salvia sclareoides Brot
- Regular Articles
- Recent Microextraction Techniques for Determination and Chemical Speciation of Selenium
- Regular Articles
- Compost leachate treatment using polyaluminium chloride and nanofiltration
- Regular Articles
- Facile and Effective Synthesis of Praseodymium Tungstate Nanoparticles through an Optimized Procedure and Investigation of Photocatalytic Activity
- Regular Articles
- Computational Study on Non-linear Optical and Absorption Properties of Benzothiazole based Dyes: Tunable Electron-Withdrawing Strength and Reverse Polarity
- Regular Articles
- Comparative sorption studies of chromate by nano-and-micro sized Fe2O3 particles
- Regular Articles
- Recycling Monoethylene Glycol (MEG) from the Recirculating Waste of an Ethylene Oxide Unit
- Regular Articles
- Antimicrobial activity and thiosulfinates profile of a formulation based on Allium cepa L. extract
- Regular Articles
- The effect of catalyst precursors and conditions of preparing Pt and Pd-Pt catalysts on their activity in the oxidation of hexane
- Regular Articles
- Platinum and vanadate Bioactive Complexes of Glycoside Naringin and Phenolates
- Regular Articles
- Antimicrobial sesquiterpenoids from Laurencia obtusa Lamouroux
- Regular Articles
- Comprehensive spectroscopic (FT-IR, FT-Raman, 1H and 13C NMR) identification and computational studies on 1-acetyl-1H-indole-2,3-dione
- Regular Articles
- A combined experimental and theoretical study on vibrational and electronic properties of (5-methoxy-1H-indol-1-yl)(5-methoxy-1H-indol-2-yl)methanone
- Regular Articles
- Erratum to: Analysis of oligonucleotides by liquid chromatography with alkylamide stationary phase
- Regular Articles
- Non-isothermal Crystallization, Thermal Stability, and Mechanical Performance of Poly(L-lactic acid)/Barium Phenylphosphonate Systems
- Regular Articles
- Vortex assisted-supramolecular solvent based microextraction coupled with spectrophotometric determination of triclosan in environmental water samples
- Regular Articles
- Investigation on Two Compounds of O,O’-dithiophosphate Derivatives as Corrosion Inhibitors for Q235 Steel in Hydrochloric Acid Solution
- Regular Articles
- Evaluation of temporary seasonal variation of heavy metals and their potential ecological risk in Nzhelele River, South Africa
- Regular Articles
- Synthesis, characterization, second and third order non-linear optical properties and luminescence properties of 1,10-phenanthroline-2,9-di(carboxaldehyde phenylhydrazone) and its transition metal complexes
- Regular Articles
- Spectrodensitometric simultaneous determination of esomeprazole and domperidone in human plasma
- Regular Articles
- Computer-aided drug design of capuramycin analogues as anti-tuberculosis antibiotics by 3D-QSAR and molecular docking
- Regular Articles
- Synthesis, characterization, thermal degradation and urease inhibitory studies of the new hydrazide based Schiff base ligand 2-(2-hydroxyphenyl)-3-{[(E)-(2-hydroxyphenyl)methylidene]amino}-2,3-dihydroquinazolin-4(1H)-one
- Regular Articles
- Quaternary salts derived from 3-substituted quinuclidine as potential antioxidative and antimicrobial agents
- Regular Articles
- Bio-concentration of Polycyclic Aromatic Hydrocarbons in the grey Mangrove (Avicennia marina) along eastern coast of the Red Sea
- Regular Articles
- Quantitative Investigation of Roasting-magnetic Separation for Hematite Oolitic-ores: Mechanisms and Industrial Application
- Regular Articles
- Photobleaching characteristics of α-(8-quinolinoxy) zinc phthalocyanine, a new type of amphipathic complex
- Regular Articles
- Methane dry reforming over Ni catalysts supported on Ce–Zr oxides prepared by a route involving supercritical fluids
- Regular Articles
- Thermodynamic Compatibility, Crystallizability, Thermal, Mechanical Properties and Oil Resistance Characteristics of Nanostructure Poly (ethylene-co-methyl acrylate)/Poly(acrylonitrile-co-butadiene) Blends
- Regular Articles
- The crystal structure of compositionally homogeneous mixed ceria-zirconia oxides by high resolution X-ray and neutron diffraction methods
- Topical Issue on Agriculture
- Properties of the filtrate from treatment of pig manure by filtration method
- Topical Issue on Agriculture
- Monitoring content of cadmium, calcium, copper, iron, lead, magnesium and manganese in tea leaves by electrothermal and flame atomizer atomic absorption spectrometry
- Topical Issue on Catalysis
- Application of screen-printed carbon electrode modified with lead in stripping analysis of Cd(II)
- Topical Issue on Research for Natural Bioactive Products
- Burdock (Arctium lappa) Leaf Extracts Increase the In Vitro Antimicrobial Efficacy of Common Antibiotics on Gram-positive and Gram-negative Bacteria
- Topical Issue on Research for Natural Bioactive Products
- A survey of bacterial, fungal and plant metabolites against Aedes aegypti (Diptera: Culicidae), the vector of yellow and dengue fevers and Zika virus
- Topical Issue on Research for Natural Bioactive Products
- ‘Capiture’ plants with interesting biological activities: a case to go
- Topical Issue on Research for Natural Bioactive Products
- Volatile terpenoids as potential drug leads in Alzheimer’s disease
- Topical Issue on Research for Natural Bioactive Products
- Essential Oils as Immunomodulators: Some Examples
- Topical Issue on Research for Natural Bioactive Products
- Phenolic profiling and therapeutic potential of local flora of Azad Kashmir; In vitro enzyme inhibition and antioxidant
- Topical Issue on Research for Natural Bioactive Products
- Chemical profile, antioxidant activity and cytotoxic effect of extract from leaves of Erythrochiton brasiliensis Nees & Mart. from different regions of Europe





